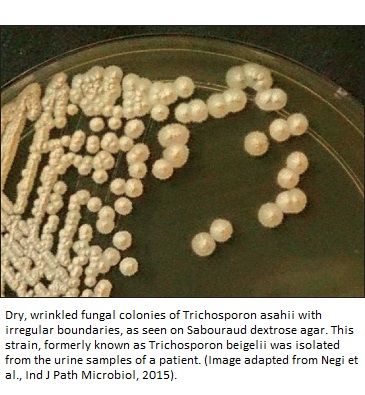

Posted 12/12/2020
Written by Molecular Biologist Dr. Vibhuti Rana, PhD
The term Trichosporon has been derived from the combination of two Greek words- Trichos (hair) and sporon (spores). This nomenclature is directly connected to its discovery as a causative agent of fungal infection White Piedra in humans (1). Genus Trichosporon belongs to phylum Basidiomycota. It is a yeast-like fungus and diverse in distribution. According to the most recent studies, in humans, species of this fungus are also found rarely as a part of microflora of gastrointestinal and oral cavity. Alternatively, these can also colonize in the human respiratory tract, skin, and vagina (3). Besides, Trichosporon spp. have also been reported as causal agents of allergic pneumonitis and invasive infection (1).
White Piedra is characterized by presence of whitish and soft nodules along the hair of head, beard or body (2). This, along with other Trichosporon infections have been documented that the patients with neutropenia, HIV infection, organ transplantation, diabetes, end-stage renal disease, deep burns, and those under the treatment involving use of hormones/immunosuppressive agents or use of invasive medical equipments are at high risk of infections by Trichosporon spp. (4).
Trichosporon spp. are known to occupy a vast range of habitats such as soil, water bodies, decomposing wood, bird droppings as well as various parts of human body (1). This fungus is mainly found in warm regions that experience tropical temperature (3). It is characterized by its ability to form arthroconidia, blastoconidia, hyphae, and pseudohyphae. The species of this genus hold the ability to absorb different carbohydrates and carbon sources as well as to degrade urea. If you happen to check out its morphology, the colonies usually grow like yeast colonies on Sabouraud dextrose agar medium and vary in color from white to cream showing specific characteristics such as cerebriform and radial surfaces (5).
The discovery of the organism dates back to year 1865 when Beigel identified it causing white Piedra in humans. However, that time, the etiological agent of this disease was incorrectly classified as an alga Pleurococcus beigelii (6). Later, 1890, Behrend undertook a detailed study on this organism causing White Piedra in man’s beard and renamed it as Trichosporon ovoides (7).
Thereafter, with the advancement in taxonomic studies, various species of Trichosporon have been recorded causing different types of infections in humans (8, 9, 10, 11). Presently, there are about 50 species belonging to the genus Trichosporon. Some of these are T. cutaneum, T. mucoides, T. asahii, T. gamsii, T. asteroides, T. dehoogii, T. inkin, T. ovoides, T. vadense, T. smithiae, T. scarabaeorum, T. domesticum, and T. montevideense. About 16 species of this genus are known to be infection-causing agents (4, 12).
Several reports demonstrate infections caused by different species of Trichosporon. This genus is mainly associated with three types of infections viz., superficial, invasive, and allergic pneumonia. White Piedra is the main superficial infection caused by various species of Trichosporon. Invasive infections include urinary tract infections, fungemia, peritonitis, and endocarditis, etc. while summer-type hypersensitivity pneumonitis is a kind of allergic infection caused by the species of this genus.
White Piedra: It is an asymptomatic superficial infection which forms whitish or brownish irregular nodules on the hair shaft. This infection is also known as trichomycosis nodularis, trichomycosis nodosa or tinea nodosa (13). It mostly affects the people of tropical and temperate climates, especially the children, young adults, and women. Lengthy hair, poor hygiene, humid hair or use of head bands may lead this infection. White Piedra is commonly caused by T. inkin (pubic hair), T. cutaneum, T. ovoides, and T. loubieri (head hair) (5). Besides, T. cutaneum, T. asahii, and T. beigelii have also been reported to cause onychomycosis (discoloration and thickening of nails) in immunocompromised patients (1, 14, 15, 16, 17). T. asteroids and T. cutaneum are the main causal agents of superficial infections of skin (6).
Invasive Infections: Trichosporon spp. are known to invade the gastrointestinal and respiratory tract as well as colonize and proliferate there. There are three forms of invasive infections: disseminated disease, infections limited to major organs, and catheter mediated infections that do not affect the tissues (3). These may include urinary tract infections, peritonitis, fungemia, and endocarditis (1).
Earlier, trichosporonosis or Trichosporon invasive infections were reported as the second most common cause of yeast infections after Candida in patients with hematological malignancies. However, with the advancement of prophylactic treatments, the occurrence of these infections has reduced (18, 19).
Majority of the infections caused by Trichosporon species are deeply seated and dispersed; so, are difficult to detect. The invasive infection-causing species of Trichosporon are T. asahii and T. mucoides. These types of infections are opportunistic and life threatening with 42% to 90% mortality rates (20, 21).
A high rate of mortality has been observed in immunosuppressed patients. Alternatively, patients with burns, hematological malignancies or organ transplants (3, 22). A neonatal case of T. asahii was also reported to cause infection by colonizing in pharynx and perineum which was subsequently treated with amphotericin B (22).
Allergic pneumonia: The allergic pneumonia caused by Trichosporon spp. has been documented mainly in immunocompetent hosts (3). This condition may be associated with chronic pneumonia, endocarditis, meningitis, and summer-type hypersensitivity pneumonitis (SHP). This type of infection is known to be caused by T. asahii. There are reports of its occurrence by T. asahii in patients with kidney transplants treatment, hematologic malignancies, in HIV positive patient (23, 24, 25). Afsari and co-workers have also reported hemorrhagic and necrotic bronchopneumonia in an immunocompromised patient (26).
In general, the diagnosis of Trichosporon infection involves two terminologies: “proven invasive trichosporonosis” and “probable invasive trichosporonosis” (1). These two cases were characterized by Girmenia et al in the patients with hematological malignancies while the revised definitions of ‘proven’ and ‘probable’ invasive infections were given by de Pauw and collaborators (20, 27).
The infection is considered as proven invasive trichosporonosis if the blood culture or cerebrospinal fluid culture of a patient yields Trichosporon spp., patients shows the signs and symptoms of infection, or the biopsy specimen culture yields Trichosporon spp. or its compatible fungal species. On the other hand, cases of probable invasive trichosporonosis include three factors - presence of any risk factor such as treatment with immunosuppressive drug (s), persisting fever, neutropenia; presence of fungal species compatible to the Trichosporon spp. in culture or any biological material.
Diagnosis of invasive and superficial infections is generally done based on the presence of microscopic elements associated with the Trichosporon spp. such as hyphae, pseudohyphae, blastoconidia, and arthroconidia in the cultures or tissue biopsy specimen (1). The testing includes complete blood count, urine analysis, renal and liver function. In the absence of any fungi, ‘Probable’ pulmonary infections are diagnosed by recovery of Trichosporon spp. and presence of pulmonary infiltrates in sputum or bronchoalveolarlavage (BAL) fluid samples.
Let me brief you about the laboratory techniques for the detection of Trichosporon spp. The first one is antigen detection. It is quite useful for the diagnosis of Trichosporon infection in early stages. The presence of glucuronoxylomannan in the cell wall of Trichosporon strains leads to cross reaction with antigens of Cryptococcus neoformans in the sera of patient who is infected with Trichosporon spp. (1, 3).
Apart from this, fast and reliable molecular techniques like polymerase chain reaction, DNA-based microarrays, pyrosequencing, and flow cytometry are also being used for the diagnosis of trichosporonosis (1, 3, 28, 29). Imaging techniques including X-ray and CT scan are undertaken for the organ associated with the problem such as chest, abdomen, or pelvis. An echocardiogram is also done if patient is suspected with endocarditis. In the case of lung infection, bronchoscopy with lavage is advised (3).
Implementation of anti-fungal therapies is the first choice for various Trichosporon infections. Unfortunately, this treatment may also lead to reoccurrence of the disease in case of White Piedra. Therefore, complete shaving of hair or removal of nodules is the better suggested treatment (1).
Nevertheless, patients not willing to shave are given oral itraconazole once a day for of three to four weeks in addition to the first-line topical antifungal treatment comprising of 2% miconazole or 2% ketoconazole daily for two weeks (3). In case of patients who are allergic or resistant to azoles, 6% precipitated sulfur in white petrolatum or 2% selenium sulfide foam is used (30).
Voriconazole has been reported as the most effective drug to manage trichosporonosis in neutropenic patients and those suffering with disseminated disease while itraconazole and fluconazole are used as the second line treatment. A combination of amphotericin and voriconazole/5-flucytosine is another recommended treatment. Trichosporonosis is not treatable with echinocandins (3).
Combination therapy of amphotericin B with voriconazole or micafungin or caspofungin is also used to treat trichosporonosis but has some limitations. It responds well against some strains while effective activity has not been documented in case of neutropenic patients (5).
To conclude, I would point out that while the infections caused by the species of genus Trichosporon are increasing globally, its diagnosis is a major challenge. This can be attributed to incorrect identification of the strains or infection types. Several techniques have been developed for the diagnosis; various trials are being conducted for the treatment; still, a lot more is needed to be investigated to decrease the mortality rate due to Trichosporon infections.

Dr. Vibhuti Rana completed her Bachelors's Degree (Bioinformatics Hons.) from Punjab University and accomplished her Master’s Degree (2012) in Genomics with a Gold Medal from Madurai Kamaraj University, India. In 2020, she received her doctorate in Molecular Biology from the Council of Scientific and Industrial Research-Institute of Microbial Technology in affiliation with the Jawaharlal Nehru University, New Delhi, India.
Her focus areas include microbial drug resistance, epidemiology, and protein-protein interactions in infectious diseases. As a Molecular Biologist with extensive experience with infectious diseases, we are happy she is part of the YeastInfectionAdvisor team.
Back to Yeast Species and Infections
Any questions about Trichosporon or yeast infections in general, please feel free to contact us from the contact page of this website or talk to your doctor.
Dr. Rana's Medical References
Home Privacy Policy Copyright Policy Disclosure Policy Doctors Store
Copyright © 2003 - 2025. All Rights Reserved under USC Title 17. Do not copy
content from the pages of this website without our expressed written consent.
To do so is Plagiarism, Not Fair Use, is Illegal, and a violation of the
The Digital Millennium Copyright Act of 1998.